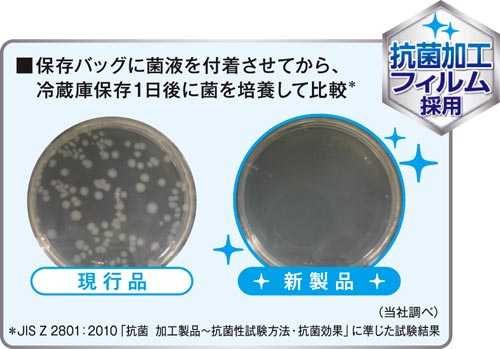

商品仕様
| 商品番号 | KWN-42737896 |
| メーカー型番 | 261049 |
| JAN | 4903301261049 |
| メーカー名 | ライオン株式会社 |
| 梱包形態 | 1個入り / 完全梱包 3個入り / 完全梱包 5個入り / 完全梱包 10個入り / 完全梱包 |
商品説明
商品説明
抗菌加工フィルム採用で清潔に使えます。冷蔵も、冷凍も、つくりおきも!レンジ解凍もOKです。●寸法/縦206×横178mm
●厚さ/0.06mm
●容量/20枚
●材質/ポリエチレン
●耐熱温度/90℃
●耐冷温度/-60℃
●単位/1箱(20枚入)
注意事項
※メーカーの都合によりパッケージが予告なく変更される場合があります。